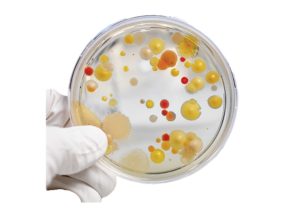

In-Line Bacterial Water Scanner
This bacterial imaging system detects and automatically counts all bacteria in a flow of water or other liquids in real time. It gives accurate, repeatable and continuous measurements of total count of all bacteria and micro-particles at 1 minute intervals. This is achieved through its in-line sampling configuration, extremely fast water imaging and advanced AI algorithm.
This real-time, automated and continuous bacterial water scanner is a game changer!
The water and beverage industries measure potable waters’ total bacteria counts and micro-particle counts for health, compliance and plant operation purposes.
Current procedures for measuring bacteria counts are mostly manual, complex and only produce results 1to3 days after the event. This new imaging system produces accurate and reliable total bacteria count results automatically and without sampling gaps, every minute!

The in-line Bacterial Water Scanner is an automated monitoring system that uses patented Direct Imaging technology and AI image processing for real-time detection and counting of bacteria and micro particles in water. It operates continuously without sampling gaps and is fully automatic, without requiring human intervention. This reagent-free analyser is highly cost effective with minimal maintenance requirements. The analysis cartridge is replaced monthly to prevent sample contamination. The analysis methodology is to single cell / particle level, giving maximum sensitivity.
The system is robust, allowing installation in water sites and production lines and even in unmanned water sites. It can be installed at any point in a simple bypass. Self-calibration procedures maintain operating accuracy, and automated recovery from power failures. The user sets the threshold for the maximum allowed number of bacteria. When the threshold is crossed the system immediately sends an alert enabling immediate reaction to irregular events. In municipal and industrial water systems the in-line Bacterial Water Scanner is used to minimize the risk and impacts of contamination events. It enables the user to understand and manage out-of-spec events by having the exact start and end time of the event and the counts magnitudes. This continuous real-time monitoring offers validation and optimization of water treatment processes such as optimization of chlorination of filtration usage, and operational validation of each of the upstream and downstream water treatment phases.

The Micro-Particle Detector counts all micro particles from 0.3 to 15 microns and provides an analysis of particle size distribution. It gives broader and clearer data than turbidity measurements and it operates in parallel to the bacterial detector. The Detector also presents the particles size distribution in 3 micron intervals. Applications include the immediate detection of an increase in the level of certain particle size which may indicate a breach of the filtration system or other water treatment process, and monitoring the particles count in the water source for out of spec deviations from normal baseline. In summary, the Bacteria Water Scanner makes around 1,500 automatic measurements per day enabling unprecedented water quality management.
New standard of Monitoring
Detects ALL bacteria
Real-time results – rapid reaction to irregular events
Eliminates sampling gaps – by continous 24/7 monitoring
In-line sampling – most accurate sampling method
Autonomous – no need for a operator
Reagent-free – cuts down the cost and logistics of using biohazard materials
Low operational cost and various cost saving – chemicals, time, energy, resources, etc.
Multiparameter – three simulations parameters.
